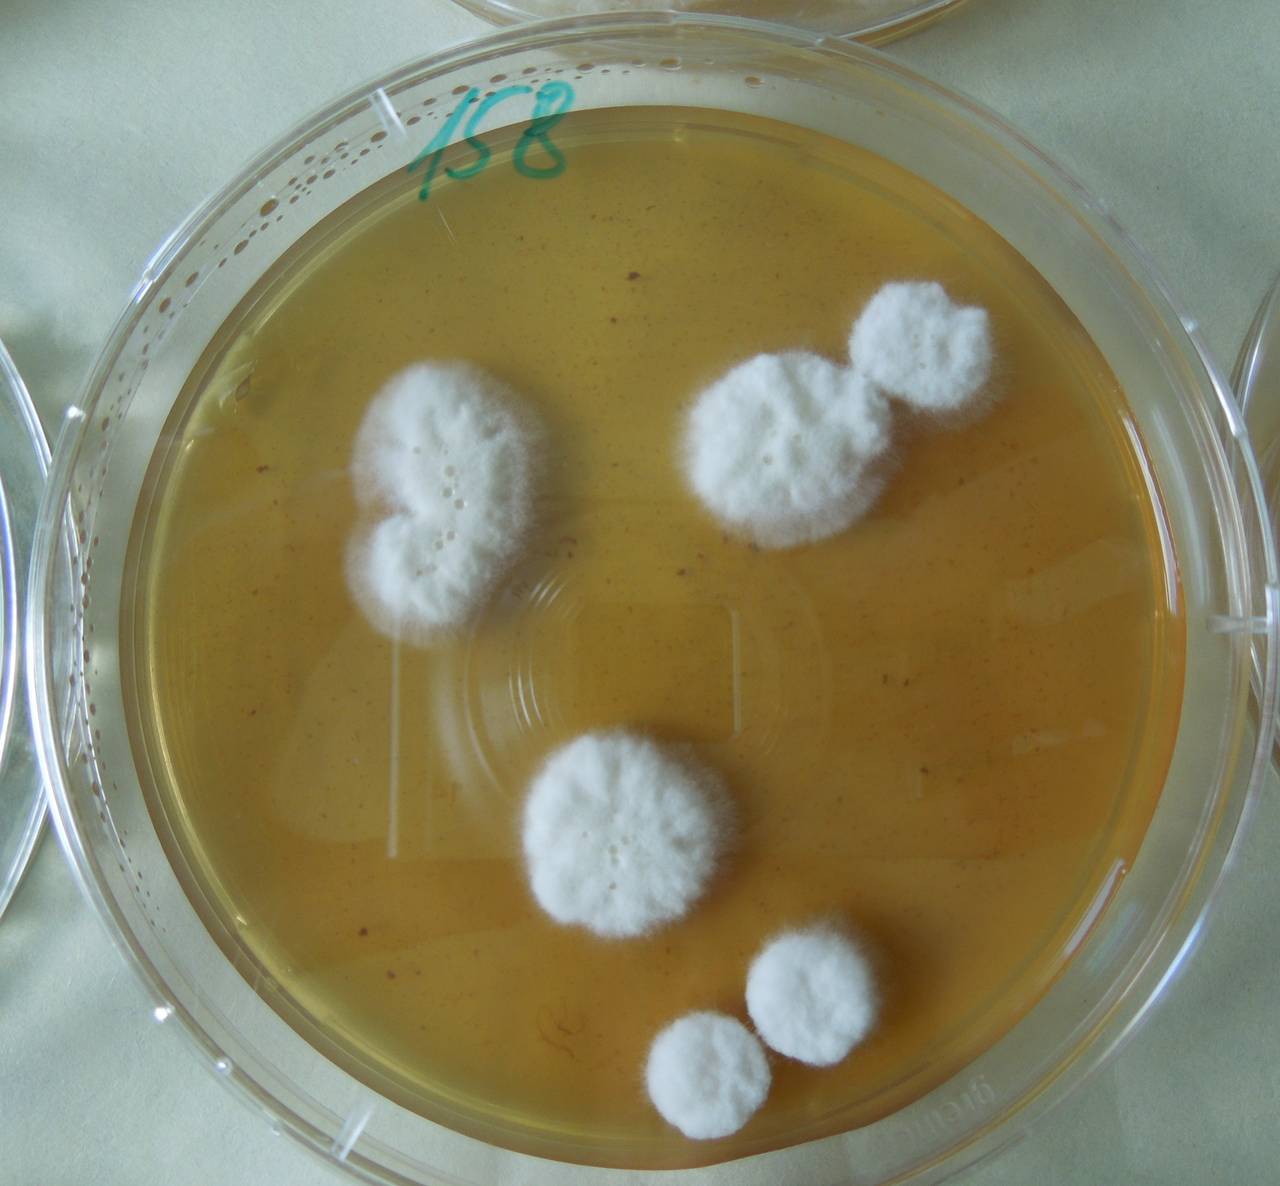
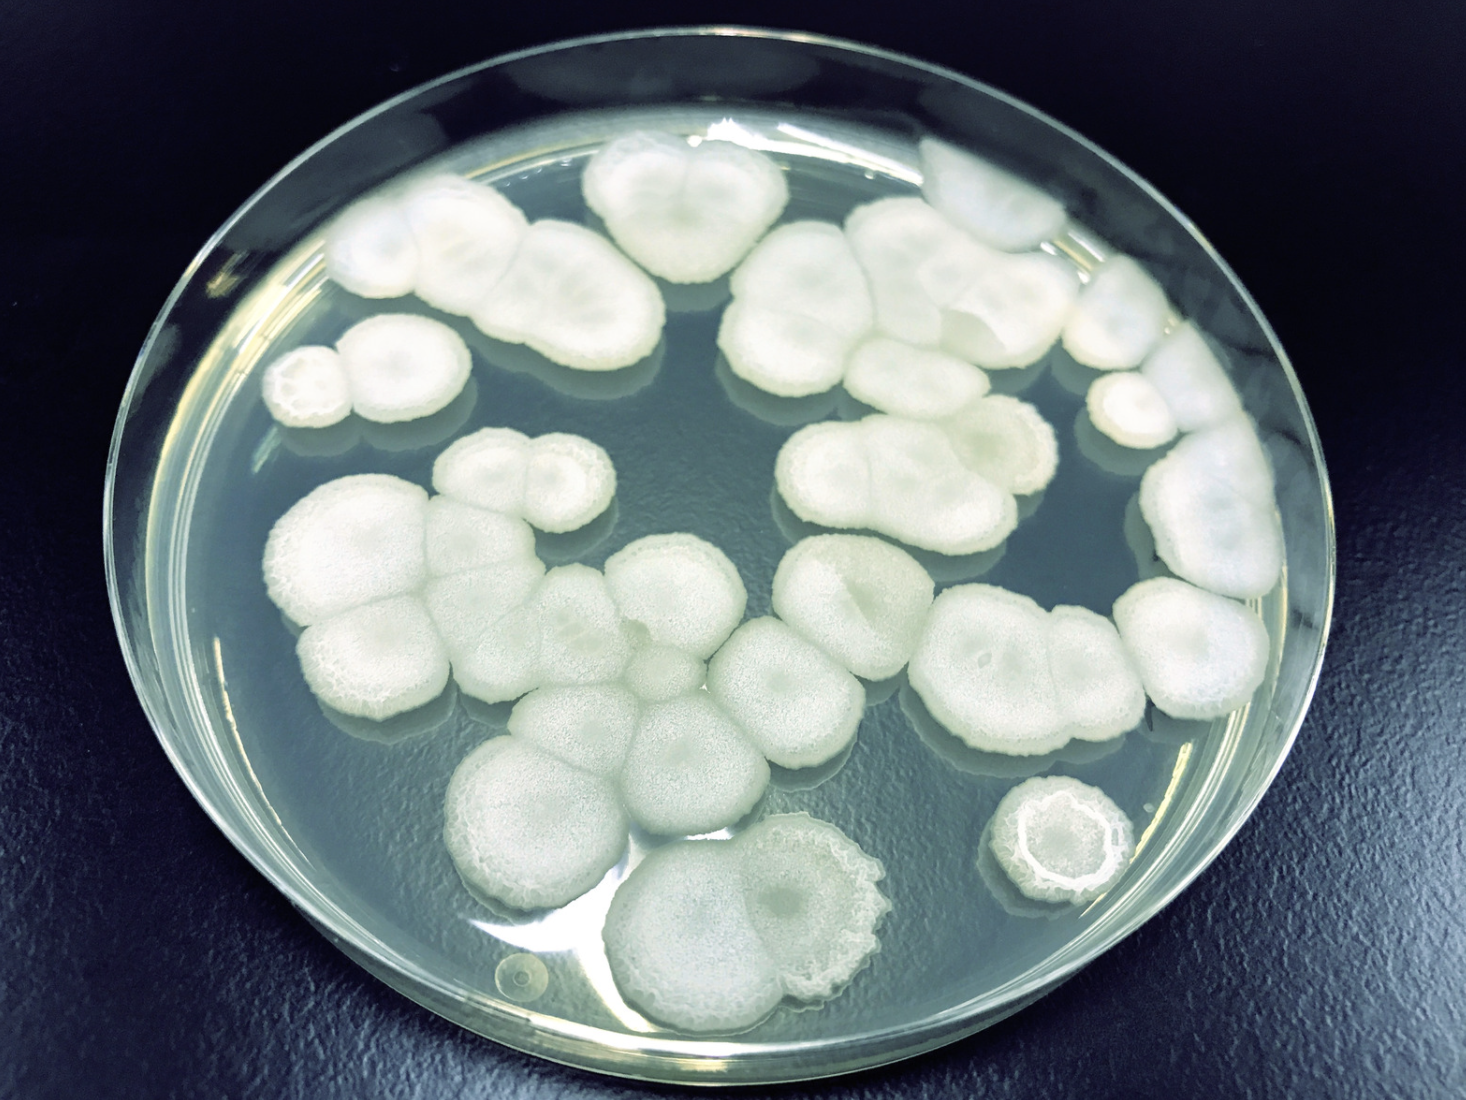

Грибы боверия
Замуж за друга детства
Сетка спицами схемы простые
Стали чк
Кубус адрес
Скоро будет списана комиссия открытие
Кинотеатр полежаевская сеансы
Станция профилактической дезинфекции
Он спасательный круг мечта твоих подруг
Где искать тетерева осенью
А ты к нему попала
Нцс водоснабжение
Перераспределение функций вверх
Пикамилон инструкция по применению побочные действия
Грибы боверия 105 фото